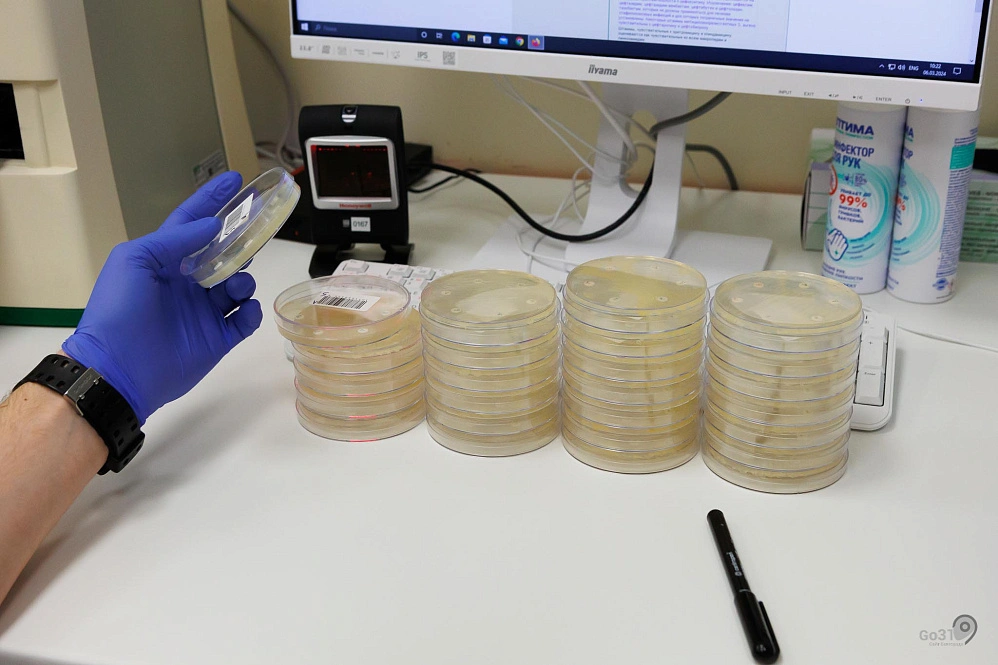

Зачем нужны микробиологические исследования пациентов

Фото: Антон Вергун
Есть работа медиков, которая часто остаётся за кадром. Например, мало кто знает, куда поступает принесённая на анализ моча, кал или мокрота. Люди оставляют анализы в поликлинике или баночки в стационаре и потом просто видят результат. Нам стало любопытно, что происходит с биоматериалом дальше. Мы побывали в белгородской областной бактериологической лаборатории, которая обслуживает жителей всего региона. О том, какие исследования здесь проводятся и в чём их значимость, рассказала заведующая Валерия Шумакова.
Современная баклаборатория больше напоминает научно-исследовательский центр, чем место, где изучают биологический материал человека. Светлые просторные помещения, какие-то приборы, внутрь которых ставятся пробирки, тихо работающие автоматы, анализирующие материал, люди в белых халатах, внимательно рассматривающие стёклышки под микроскопом. Здесь проводят анализ на наличие вирусов, бактерий, грибов и паразитов. Современные методы исследований позволяют белгородским бактериологам выявлять не только часто встречающиеся патогены, но и редкие возбудители, а это порядка 3 000 видов различных микроорганизмов.
Нам показывают стёкла, на которых видно что-то, похожее на плесень. Они называются чашечками Петри. Биологический материал помещают на питательную среду и создают подходящие условия для роста. Скоро в них появляются целые колонии микроорганизмов. На них начинают воздействовать разными антимикробными препаратами. На некоторых стёклышках видно, что плесень съёжилась и отползла от центра. Это значит, что бактерии показывают высокую чувствительность к антибиотикам. А на других плесень продолжает активно жить и развиваться, несмотря на лекарство. Не повезло какому-то больному, с сожалением подумали мы. Антибиотикорезистентность – штука крайне неприятная.
Сегодня исследования на чувствительность микроорганизмов к антибиотикам актуальны как никогда. Рост резистентности к антимикробным препаратам наблюдается во всём мире. По статистике ежегодно 700 тыс. человек умирает от болезней, вызванных бактериями, не чувствительными к антибиотикам.
По словам главного внештатного специалиста по клинической микробиологии Министерства здравоохранения РФ Романа Козлова, к 2050 году по этой причине в мире умрёт более 10 млн человек. Вот почему так важно не назначать самому себе антимикробные препараты. А если их прописал доктор, необходимо полностью пропить весь курс.

Мы проводим исследования на чувствительность к антибиотикам, чтобы врач мог правильно назначить лечение, узнав причину заболевания. Если доктор понимает, что это вирусная инфекция, антибиотики он назначать не будет. Они эффективны только при антибактериальной терапии,
– говорит Валерия Шумакова.
Бактериологическая лаборатория помогает эффективно бороться с возбудителями инфекций и участвует в лечебном процессе. Сегодня работа любой многопрофильной больницы хирургического направления невозможна без бактериологического отдела. Он играет огромную роль в постановке диагноза, выборе лекарственного препарата для борьбы с инфекцией, а также в контроле внутрибольничной инфекции. .
В прошлом году в белгородской баклаборатории прошло более 270 тыс. микробиологических исследований. Анализов на ПЦР (полимеразная цепная реакция – это один из самых точных методов молекулярно-генетической диагностики), было сделано около 250 тыс., включая не только тесты на ковид, но и все молекулярно-биологические исследования. И ещё специалисты провели около 13 тыс. исследований на обнаружение паразитов.
Записала Виктория Передерий
Фото: Антон Вергун


